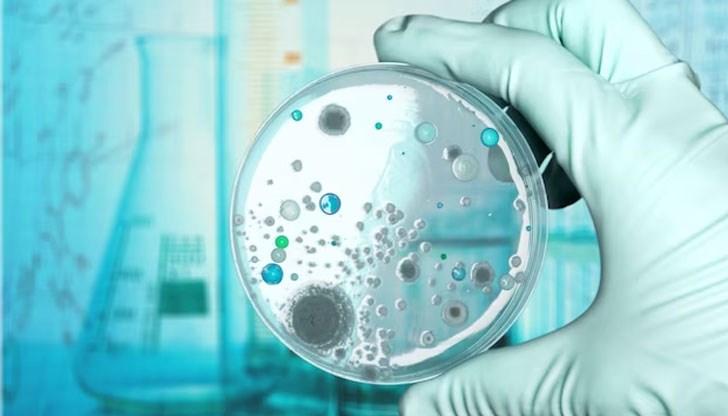
Тези бактерии се разпространяват бързо и в голям географски мащаб Тези бактерии се разпространяват бързо и в голям географски мащаб

"Нова заплаха за Европа": Учени предупреждават за устойчива на антибиотици бактерия
- Редактор: Петя Георгиева
- Коментари: 3
Тези бактерии се разпространяват бързо и в голям географски мащаб
Увеличаващите се случаи на определени видове устойчиви към антибиотици бактерии Ешерихия коли представляват нова заплаха за страните от Европейския съюз (ЕС)/Европейското икономическо пространство (ЕИП), предупреди Европейският център за профилактика и контрол върху заболяванията, цитиран от Синхуа.
Държави на Стария континент съобщават за нарастващ брой на видовете Ешерихия коли, носещи гена blaNDM-5, който ги прави резистентни към карбапенеми - вид антибиотици, често използвани при сериозни инфекции, предизвикани от тези бактерии, се казва в прессъобщението на институцията, предаде БТА.
Освен това голяма част от тези щамове на Ешерихия коли са резистентни и към други групи антибиотици, което допълнително ограничава възможностите за лечение.
Въпреки че устойчивостта към карбапенеми в европейските страни е ниска, неотдавнашно проучване показва, че щамовете Ешерихия коли с гена blaNDM-5 "вече са се установили и представляват нова заплаха" за региона.
Подобни бактерии "се разпространяват бързо и в голям географски мащаб", като съществува риск броят на случаите на резистентни към карбапенеми инфекции с Ешерихия коли да се увеличат в рамките на няколко години.
Тези бактерии обичайно се срещат в стомашно-чревния тракт на човешкото тяло и са част от нормалната бактериална флора при хората, но могат да причинят и тежки инфекции, особено на кръвта и пикочните пътища.
По данни на Европейския център за профилактика и контрол върху заболяванията повече от 35 000 души на Стария континент умират всяка година от антимикробно резистентни инфекции.




















